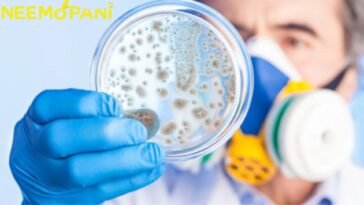
Superbugs: Another silent pandemic
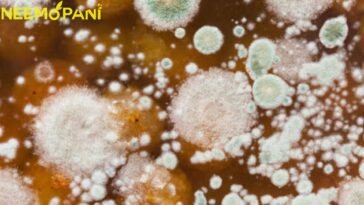
Dangerous Fungi Spread

Science
We are a science-based company with a mission to make life better for all those who suffer from migraine and related headaches. We focus our efforts on the underlying causes of migraines and develop practical, effective treatments.
Science is an internationally renowned, peer-reviewed general scientific journal in the fields of natural science and engineering.
More stories
-
-
-
in Education, News, Science, Social Media, Technology, Twitter
Study Reveals that Infants outsmart AI
a recent study discovered that newborns are superior to AI when it comes to critical psychological tasks.
-
Research Shows Spending Time online is Beneficial
The research is carried out by providing smartphone devices, namely iPhones, to a sample of more than two hundred adolescents who are living in poor socioeconomic situations.
-
in Blogs, Science, World News
Scientists are stunned as a massive piece of the sun breaks off
Scientists are stunned as a massive piece of the sun breaks off.Scientists are attempting to figure out what effect this massive prominence will have on Earth.
-
Dr. Michael Ain, Who Stood Strong Despite Rejection
Orthopedic surgeon Dr. Michael Craig Ain, 59, is the sole dwarf in his middle-class Jewish family of four children. He is barely 4 feet 3 inches tall.
-
in Blogs, News, Science, World News
Saudia Arabia to send first woman to space
According to SPA and Axiom Space, Barnawi and Al-Qarni will go to the ISS in a SpaceX Dragon rocket as part of a mission this spring.
-
Superbugs: Another Silent Pandemic Coming!
By 2050, the United Nations predicts that AMR will cause up to 10 million deaths annually, and “superbugs” will be responsible for the deaths of nearly 1.27 million people each year.
-
-
Iraq: Archaeologists Found 5000-year-old fridge!
An international team of researchers plans the next steps at Lagash. Today’s archaeologists can “see” below ground with the help of cutting-edge technology, allowing them to only dig when absolutely necessary.
-
in Science, Technology
Tiny FAIRY Robot weighing 1.2 mg may serve as pollinator
The brand-new FAIRY robot, an acronym for “Flying Aero-robots based on Light Responsive Materials Assembly,” is the first flying robot we’ve seen composed of soft materials that respond to light. It weighs just 1.2 milligrammes.
-
February Won’t Be a Hoodie Season!
Beginning in February of this year, Pakistan’s Meteorological Department as well as the NOAA have both issued warnings regarding the possibility of an early start to summer.